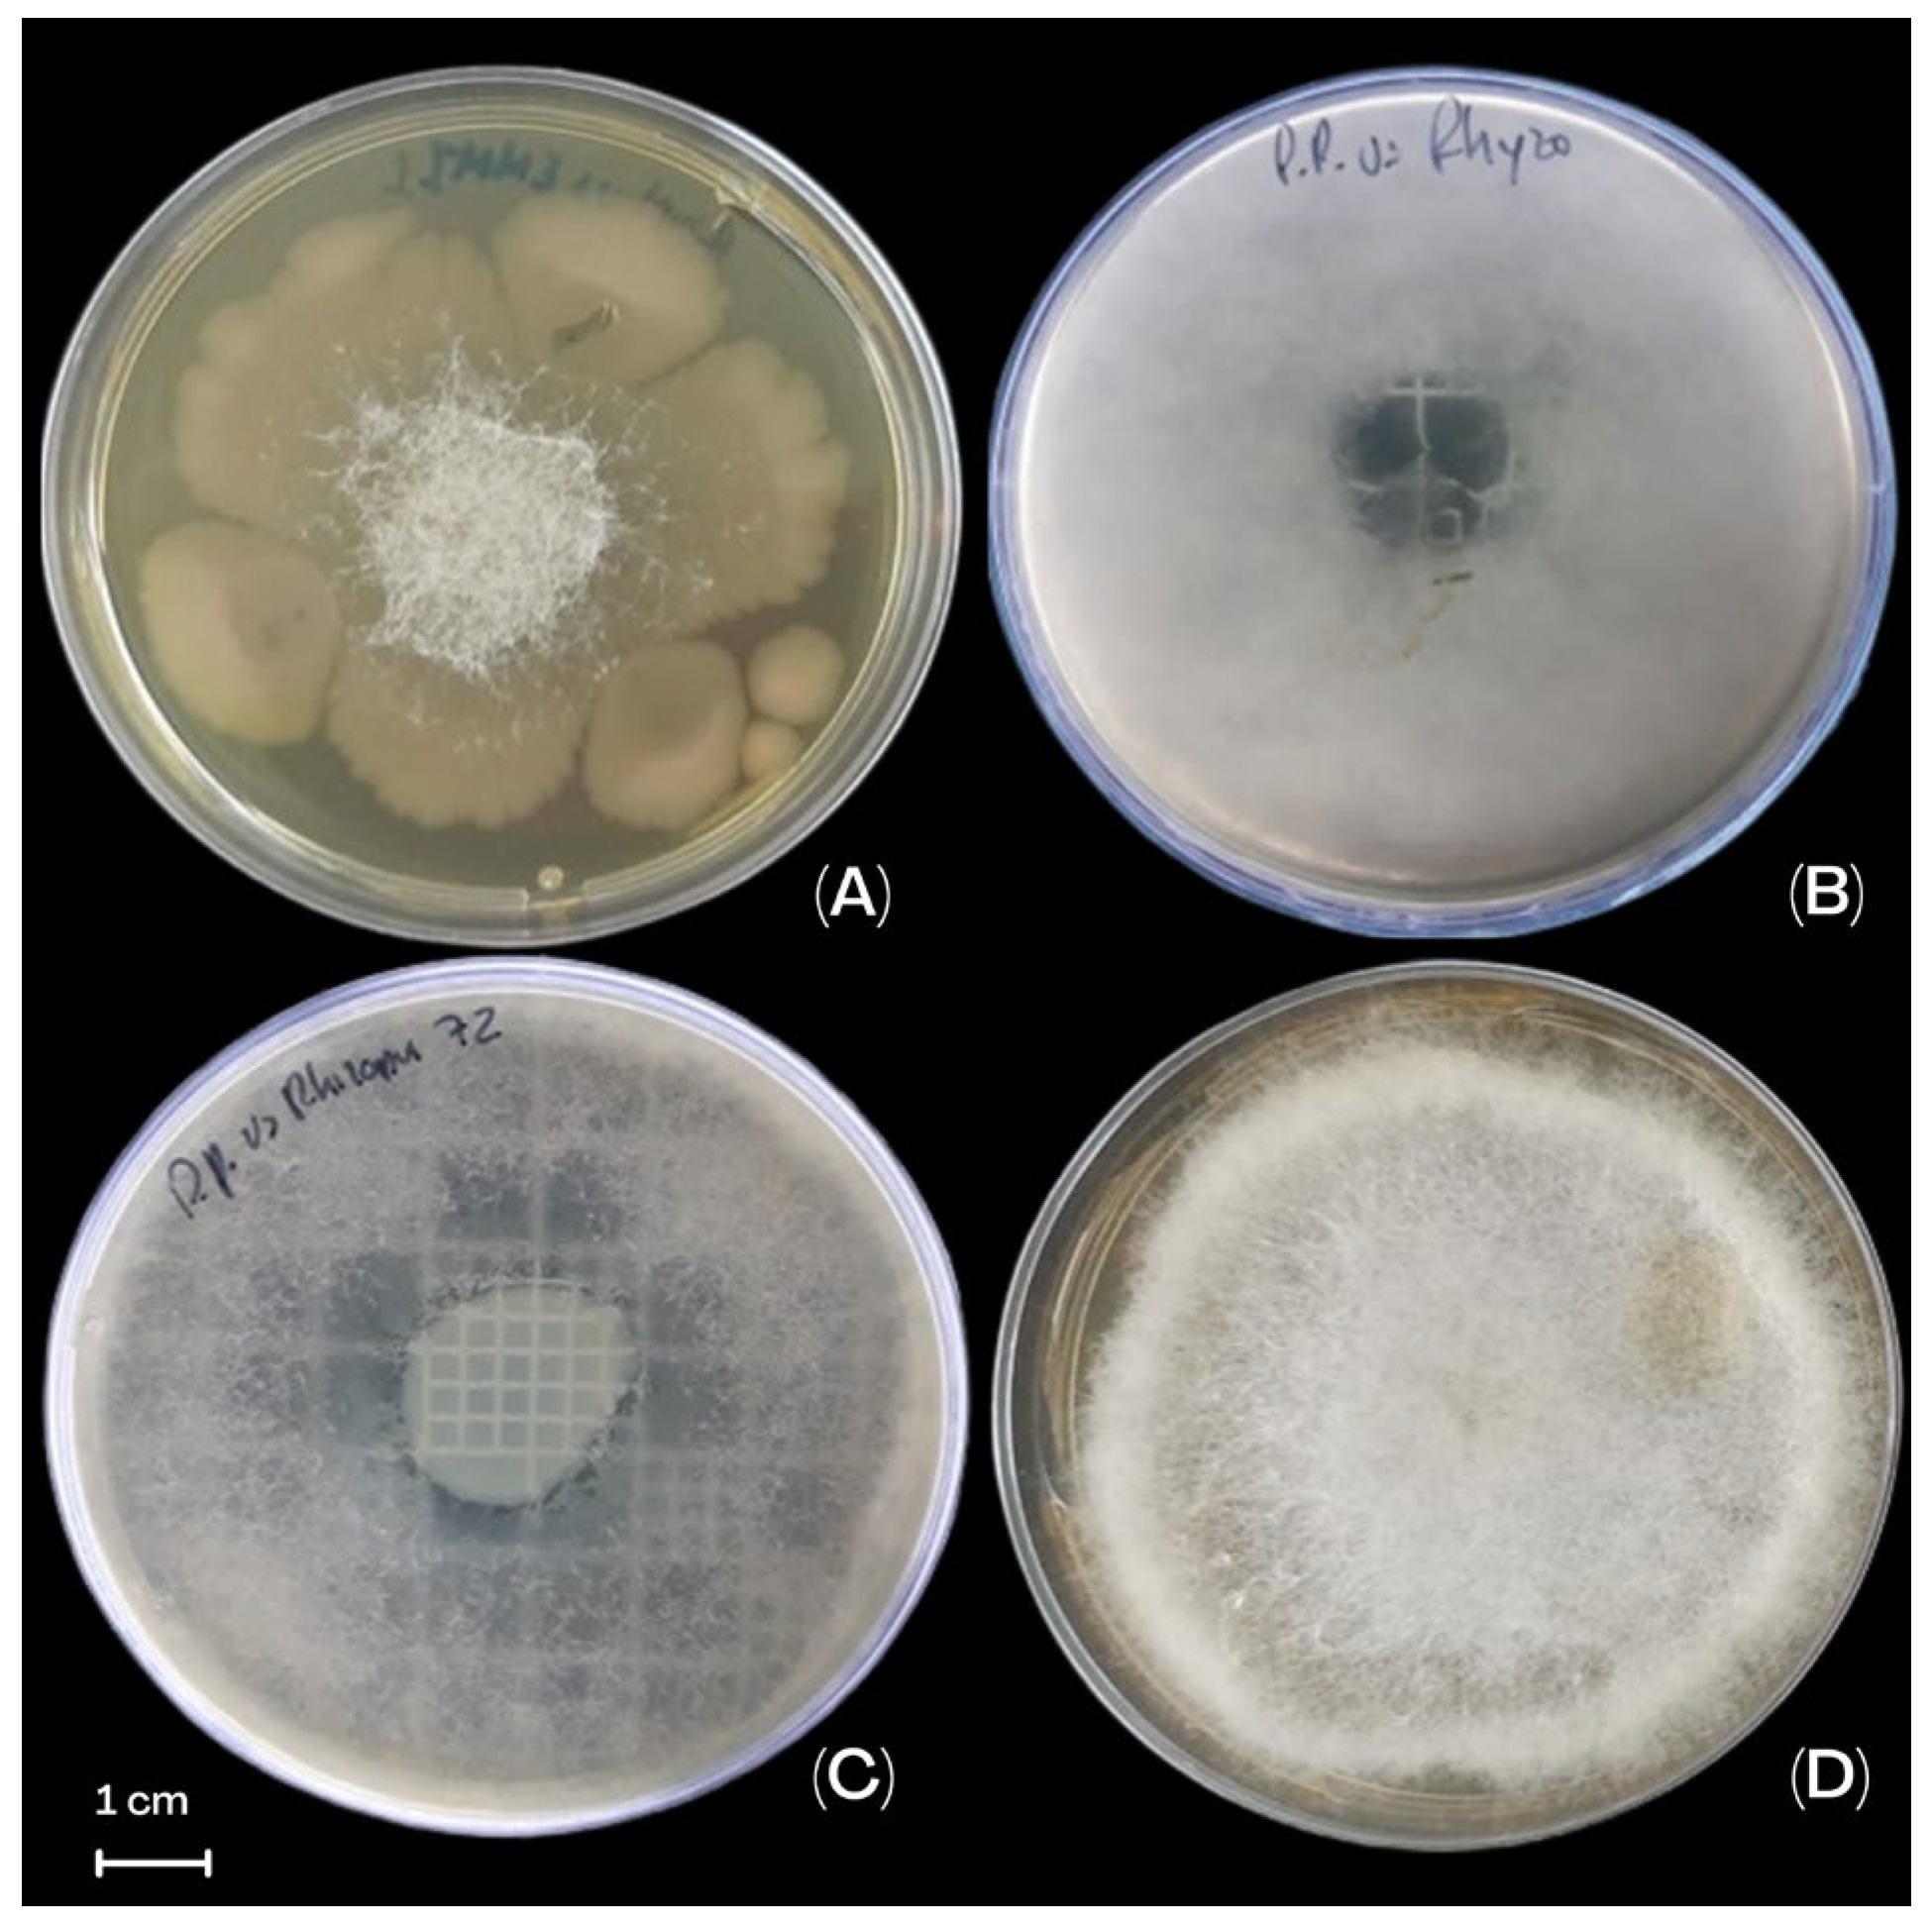
Life 15 00554 g004

Effect of Pseudomonas protegens EMM-1 Against Rhizopus oryzae in Interactions with Mexican Autochthonous Red Maize
Abstract
1. Introduction
2. Materials and Methods
2.1. Bacterial Sources
2.2. Phytopathogenic Fungi Isolation
2.3. Molecular Identification of Fungi
2.4. Pathogenicity Studies
2.5. Dual-Plate Inhibition Method
2.6. Double-Layer Agar Inhibition Method
2.7. Simultaneous Inhibition Method
2.8. Photographic and Statistical Analysis of Inhibition Plate Assays
2.9. Microbial Growth and Interaction in Liquid Medium
2.10. Plant Bioassay Preparation
2.11. Microbial Effect on Maize Plants in a Hydroponic System
2.12. Effect of Microorganisms on Maize Plant Growth in Vermiculite
2.13. Microbial Adherence and Colonization to the Roots in the Hydroponic and Vermiculite Systems
2.14. Statistical Analysis for Plants
2.15. Genome Sequencing
2.16. Genome Analysis
3. Results
3.1. Morphological Characterization of Phytopathogens Isolated from Maize Seeds
3.2. Molecular Identification of Fungal Strains
3.3. Pathogenicity Assays
3.4. The Effect of P. protegens EMM-1 Against R. oryzae EMM Under In Vitro Conditions
3.5. Microbial Interaction in Liquid Medium
3.6. Microbial Effect on Maize Plant Growth in a Hydroponic System
3.7. Microbial Adherence and Colonization to the Roots in the Hydroponic System
3.8. Microbial Effect on Maize Plants in a Vermiculite System
3.9. Microbial Adherence and Colonization to the Roots in the Vermiculite System
3.10. Genome Analysis Results
3.11. AntiSMASH Genome Analysis
3.12. Data Availability
4. Discussion
5. Conclusions
Author Contributions
Funding
Institutional Review Board Statement
Informed Consent Statement
Data Availability Statement
Acknowledgments
Conflicts of Interest
References
- Sierra Macias, M.; Andres Meza, P.; Palafox Caballero, A.; Meneses Márquez, I. Diversidad genética, clasificación y distribución racial del maíz nativo en el estado de Puebla, México. Artíc. Rev. Cienc. Nat. Agropecu. Diciembre 2016, 3, 12–21. [Google Scholar]
- Gutiérrez, L.J.; Niembro, G.C.; Reyes Gama, R.; Niembro, G.C. Evaluación Agronómica del maíz criollo rojo Guanajuato. Rev. Iberoam. Cienc. 2020, 7, 19–24. [Google Scholar]
- Guzzon, F.; Rios, L.W.A.; Cepeda, G.M.C.; Polo, M.C.; Cabrera, A.C.; Figueroa, J.M.; Hoyos, A.E.M.; Calvo, T.W.J.; Molnar, T.L.; León, L.A.N.; et al. Conservation and use of latin american maize diversity: Pillar of nutrition security and cultural heritage of humanity. Agronomy 2021, 11, 172. [Google Scholar] [CrossRef]
- Magdaleno-Hernández, E.; Mejía-Contreras, A.; Martínez-Saldaña, T.; Jiménez-Velazquez, M.A.; Sanchez-Escudero, J.; García-Cué, J.L. Selección tradicional de semilla de maíz criollo. Agric. Soc. Desarro. 2016, 13, 437–447. [Google Scholar]
- Czarnecka, D.; Czubacka, A.; Agacka-Mołdoch, M.; Trojak-Goluch, A.; Księżak, J. The occurrence of fungal diseases in maize in organic farming versus an integrated management system. Agronomy 2022, 12, 558. [Google Scholar] [CrossRef]
- Rehman, F.U.; Adnan, M.; Kalsoom, M.; Naz, N.; Husnain, M.G.; Ilahi, H.; Ilyas, M.A.; Yousaf, G.; Tahir, R.; Ahmad, U. Seed-borne fungal diseases of maize (Zea mays L.): A review. Agrinula J. Agroteknol. Perkeb. 2021, 4, 43–60. [Google Scholar]
- Kumar, D.; Kalita, P. Reducing postharvest losses during storage of grain crops to strengthen food security in developing countries. Foods 2017, 6, 8. [Google Scholar] [CrossRef]
- Mesterházy, Á.; Oláh, J.; Popp, J. Losses in the grain supply chain: Causes and solutions. Sustainability 2020, 12, 2342. [Google Scholar] [CrossRef]
- Gülmez, B. Advancements in maize disease detection: A comprehensive review of convolutional neural networks. Comput. Biol. Med. 2024, 183, 109222. [Google Scholar]
- Martínez Padrón, H.Y.; Hernández Delgado, S.; Reyes Méndez, C.A.; Vázquez Carrillo, G. The genus Aspergillus and their mycotoxins in maize in Mexico: Problems and perspectives. Rev. Mex. Fitopatol. 2013, 31, 126–146. [Google Scholar]
- Sun, X.; Yang, R.; Tang, H.; Ma, M.; Chen, H.; Chang, X.; Zhang, M.; Gong, G. Diversity and pathogenicity of Fusarium species associated with Fusarium head blight in wheat and maize cropping systems in Sichuan Province. Sci Rep. 2025, 15, 5984. [Google Scholar] [PubMed]
- Asiedu, D.D.; Miedaner, T. Genetic and Genomic Tools in Breeding for Resistance to Fusarium Stalk Rot in Maize (Zea mays L.). Plants 2025, 14, 819. [Google Scholar] [CrossRef] [PubMed]
- Xue, M.; Qu, Z.; Moretti, A.; Logrieco, A.F.; Chu, H.; Zhang, Q.; Sun, C.; Ren, X.; Cui, L.; Chen, Q.; et al. Aspergillus Mycotoxins: The Major Food Contaminants. Adv. Sci. 2025, 12, e2412757. [Google Scholar]
- Abe, C.A.L.; Faria, C.B.; De Castro, F.F.; De Souza, S.R.; dos Santos, F.C.; Da Silva, C.N.; Tessmann, D.J.; Barbosa-Tessmann, I.P. Fungi isolated from maize (Zea mays L.) grains and production of associated enzyme activities. Int. J. Mol. Sci. 2015, 16, 15328–15346. [Google Scholar] [CrossRef] [PubMed]
- Niaz, I.; Dawar, S. Detection of seed borne mycoflora in maize (Zea mays L.). Pak. J. Bot 2009, 41, 443–451. [Google Scholar]
- Sadia, S.; Shamsi, U.; ABashar, A. Prevalence of fungi associated with storage seeds of different maize varieties. Biores. Commun. 2021, 7, 1010–1018. [Google Scholar]
- García, H.G.; Marín, M.; Jaramillo, S.; Cotes, M. Sensibilidad de aislamientos colombianos de Phytophthora infestans a cuatro fungicidas sistémicos. Agron. Colomb. 2008, 26, 47–57. [Google Scholar]
- Finkel, O.M.; Castrillo, G.; Herrera Paredes, S.; Salas González, I.; Dangl, J.L. Understanding and exploiting plant beneficial microbes. Curr. Opin. Plant Biol. 2017, 38, 155–163. [Google Scholar]
- Díaz-Rodríguez, A.M.; Cota, F.I.P.; Chávez, L.A.C.; Ortega, L.F.G.; Alvarado, M.I.E.; Santoyo, G.; Santos-Villalobos, S.d.L. Microbial inoculants in sustainable agriculture: Advancements, challenges, and future directions. Plants 2025, 14, 191. [Google Scholar] [CrossRef]
- Morales-García, Y.E.; Juárez-Hernández, D.; Hernández-Tenorio, A.-L.; Muñoz-Morales, J.M.; Baez, A.; Muñoz-Rojas, J. Inoculante de segunda generación para incrementar el crecimiento y salud de plantas de jardín. Alianzas Tend. BUAP 2020, 5, 136–154. [Google Scholar]
- Morales-Barrón, B.M.; Baez, A.; Pazos-Rojas, L.A.; Schilder, K.A.; Muñoz-Rojas, J.; Morales-García, Y.E. Aislamiento de microorganismos a partir de plantas: Más allá del cultivo convencional. AyTBUAP 2023, 8, i–xi. [Google Scholar]
- Zou, J.; Whalen, J.K.; Harrison, M.T. Maize genotypes foster distinctive bacterial and fungal communities in the rhizosphere. Agric. Ecosyst. Environ. 2025, 382, 109505. [Google Scholar]
- Cesa-Luna, C.; Baez, A.; Quintero-Hernández, V.; De La Cruz-Enríquez, J.; Castañeda-Antonio, M.D.; Muñoz-Rojas, J. The importance of antimicrobial compounds produced by beneficial bacteria on the biocontrol of phytopathogens. Acta Biol. Colomb. 2020, 25, 140–154. [Google Scholar]
- Raaijmakers, J.M.; de Bruijn, I.; Nybroe, O.; Ongena, M. Natural functions of lipopeptides from Bacillus and Pseudomonas: More than surfactants and antibiotics. FEMS Microbiol. Rev. 2010, 34, 1037–1062. [Google Scholar]
- Geudens, N.; Martins, J.C. Cyclic lipodepsipeptides from Pseudomonas spp.—Biological Swiss-Army knives. Front. Microbiol. 2018, 9, 1867. [Google Scholar]
- Yang, R.; Du, X.; Khojasteh, M.; Shah, S.M.A.; Peng, Y.; Zhu, Z.; Xu, Z.; Chen, G. Green guardians: The biocontrol potential of Pseudomonas-derived metabolites for sustainable agriculture. Biol. Control 2025, 201, 105699. [Google Scholar]
- Aguado-Santacruz, G.A.; Moreno-Gómez, B.; Jiménez-Francisco, B.; García-Moya, E.; Preciado-Ortiz, R.E. Impacto de los sideróforos microbianos y fitosideróforos en la asimilación de hierro por las plantas: Una síntesis. Rev. Fitotec. Mex. 2012, 35, 9–21. [Google Scholar]
- Zakaria, E. Chitinase production by Bacillus thuringiensis and Bacillus licheniformis: Their potential in antifungal biocontrol. J. Microbiol. 2012, 50, 103–111. [Google Scholar]
- Nayak, S.K.; Nayak, S.; Mohanty, S.; Sundaray, J.K.; Mishra, B.B. Microbial chitinases and their applications: An overview. In Environmental and Agricultural Microbiology: Applications for Sustainability; Wiley: Hoboken, NJ, USA, 2021; pp. 313–340. [Google Scholar]
- Karimi, K.; Amini, J.; Harighi, B.; Bahramnejad, B. Evaluation of biocontrol potential of Pseudomonas and Bacillus spp. against Fusarium wilt of chickpea. Aust. J. Crop Sci. 2012, 6, 695–703. [Google Scholar]
- Caldera, L.; Franzetti, L.; Van Coillie, E.; De Vos, P.; Stragier, P.; De Block, J.; Heyndrickx, M. Identification, enzymatic spoilage characterization and proteolytic activity quantification of Pseudomonas spp. isolated from different foods. Food Microbiol. 2016, 54, 142–153. [Google Scholar]
- Soufi, B.; Krug, K.; Harst, A.; Macek, B. Characterization of the E. coli proteome and its modifications during growth and ethanol stress. Front. Microbiol. 2015, 6, 103. [Google Scholar]
- Stress, A.; Hemamalini, R.; Khare, S.K. Secretome Analysis of a Pseudomonas aeruginosa Strain Grown Under High Alkane Stress. Curr. Proteom. 2015, 12, 202–208. [Google Scholar]
- Cornforth, D.M.; Foster, K.R. Competition sensing: The social side of bacterial stress responses. Nat. Rev. Microbiol. 2013, 11, 285–293. [Google Scholar]
- Ma, Z.; Geudens, N.; Kieu, N.P.; Sinnaeve, D.; Ongena, M.; Martins, J.C.; Höfte, M. Biosynthesis, chemical structure, and structure-activity relationship of orfamide lipopeptides produced by Pseudomonas protegens and related species. Front. Microbiol. 2016, 7, 382. [Google Scholar]
- Ng, W. Growth of Pseudomonas protegens Pf-5 in M9 minimal salts medium. PeerJ Prepr. 2018, 1, 1–6. [Google Scholar]
- Jing, X.; Cui, Q.; Li, X.; Yin, J.; Ravichandran, V.; Pan, D.; Fu, J.; Tu, Q.; Wang, H.; Bian, X.; et al. Engineering Pseudomonas protegens Pf-5 to improve its antifungal activity and nitrogen fixation. Microb. Biotechnol. 2018, 13, 118–133. [Google Scholar]
- Galindo, E.; Serrano-carreón, L.; Gutiérrez, C.R.; Balderas-ruíz, K.A.; Muñoz-celaya, A.L.; Arroyo-colín, M.M.J. Desarrollo histórico y los retos tecnológicos y legales para comercializar FungiFree AB®, el primer biofungiciDa 100% mexicano. TIP. Rev. Espec. Cienc. Quím.-Biol. 2015, 18, 52–60. [Google Scholar]
- Elnahal, A.S.M.; El-Saadony, M.T.; Saad, A.M.; Desoky, E.S.M.; El-Tahan, A.M.; Rady, M.M.; AbuQamar, S.F.; El-Tarabily, K.A. The use of microbial inoculants for biological control, plant growth promotion, and sustainable agriculture: A review. Eur. J. Plant Pathol. 2022, 162, 759–792. [Google Scholar]
- Cesa-Luna, C.; Baez, A.; Aguayo-Acosta, A.; Llano-Villarreal, R.C.; Juárez-González, V.R.; Gaytán, P.; Bustillos-Cristales, M.d.R.; Rivera-Urbalejo, A.; Muñoz-Rojas, J.; Quintero-Hernández, V. Growth inhibition of pathogenic microorganisms by Pseudomonas protegens EMM-1 and partial characterization of inhibitory substances. PLoS ONE 2020, 15, 10. [Google Scholar]
- Morales-García, Y.E.; Juárez-Hernández, D.; Aragón-Hernández, C.; Mascarua-Esparza, M.A.; Bustillos-Cristales, M.R.; Fuentes-Ramírez, L.E.; Martinez-Contreras, R.D.; Munoz-Rojas, J. Growth response of maize plantlets inoculated with Enterobacter spp., as a model for alternative agriculture. Rev. Argent Microbiol. 2011, 43, 287–293. [Google Scholar]
- Khokhar, I.; Mukhtar, I.; Wang, J.; Jia, Y.; Yan, Y.C. A report of Rhizopus oryzae causing postharvest soft rot of apple fruit in China. Australas. Plant Dis. Notes 2019, 14, 7. [Google Scholar] [CrossRef]
- Chávez-Ramírez, B.; Rodríguez-Velázquez, N.D.; Chávez-Sánchez, M.E.; Vásquez-Murrieta, M.S.; Hernández-Gallegos, M.A.; Velázquez-Martínez, J.R.; Avendaño-Arrazate, C.H.; Santos, P.E.-D.L. Morphological and molecular identification of Phytophthora tropicalis causing black pod rot in Mexico. Can. J. Plant Pathol. 2021, 43, 670–679. [Google Scholar] [CrossRef]
- Guindon, S.; Delsuc, F.; Dufayard, J.F.; Gascuel, O. Estimating maximum likelihood phylogenies with PhyML. Methods Mol. Biol. 2009, 537, 113–137. [Google Scholar]
- Kumar, S.; Stecher, G.; Tamura, K. MEGA7: Molecular evolutionary genetics analysis version 7.0 for bigger datasets. Mol. Biol. Evol. 2016, 33, 1870–1874. [Google Scholar] [CrossRef]
- Morales-García, E.; Pazos, L.; Bustillos, M.; Krell, T.; Muñoz, J. Método rápido para la obtención de axénico a partir de semillas maíz. Elementos 2010, 80, 35–38. [Google Scholar]
- Morales-Barrón, B.M.; Vázquez-González, F.J.; González-Fernández, R.; De La Mora-Covarrubias, A.; Quiñonez-Martínez, M.; Díaz-Sánchez, Á.G.; Martínez-Martínez, A.; Nevárez-Moorillón, V.; Valero-Galván, J. Evaluación de la capacidad antagónica de cepas del orden bacillales aisladas de lixiviados de lombricomposta sobre hongos fitopatógenos. Acta Univ. 2017, 27, 44–54. [Google Scholar] [CrossRef]
- Wang, X.; Wang, J.; Jin, P.; Zheng, Y. Investigating the efficacy of Bacillus subtilis SM21 on controlling rhizopus rot in peach fruit. Int. J. Food Microbiol. 2013, 164, 141–147. [Google Scholar] [CrossRef]
- Corral-Lugo, A.; Morales-Garcia, Y.; Pazos-Rojas, L.; Ramirez-Valverde, A.; Martinez-Contreras, R.; Muñoz-Rojas, J. Cuantificación de bacterias cultivables mediante el método de “Goteo en Placa por Sellado (o estampado) Masivo”. Rev. Colomb. Biotecnol. 2012, 14, 147–156. [Google Scholar]
- Molina-Romero, D.; Juárez-Sánchez, S.; Venegas, B.; Ortíz-González, C.S.; Baez, A.; Morales-García, Y.E.; Muñoz-Rojas, J. A bacterial consortium interacts with different varieties of maize, promotes the plant growth, and reduces the application of chemical fertilizer under field conditions. Front. Sustain. Food Syst. 2021, 4, 616757. [Google Scholar] [CrossRef]
- Moore, D.; Dowhan, D. Preparation and analysis of DNA. In Current Protocols in Molecular Biology; John Wiley & Sons, Inc.: New York, NY, USA, 2003. [Google Scholar]
- Blin, K.; Shaw, S.; Augustijn, H.E.; Reitz, Z.L.; Biermann, F.; Alanjary, M.; Fetter, A.; Terlouw, B.R.; Metcalf, W.W.; Helfrich, E.J.N.; et al. antiSMASH 7.0: New and improved predictions for detection, regulation, chemical structures and visualisation. Nucleic Acids Res. 2023, 51, W46–W50. [Google Scholar] [CrossRef]
- Rosselló-Móra, R.; Amann, R. Past and future species definitions for Bacteria and Archaea. Syst. Appl. Microbiol. 2015, 38, 209–216. [Google Scholar] [CrossRef] [PubMed]
- Guzmán-Anaya, L.; Guadalupe Lugo-Sánchez, M. Analisis regional de la produccion de maíz en México. Eseconomía 2024, XIX, 9–27. [Google Scholar]
- Steffen Riedemann, C.; Echánove Huacuja, F. El maíz amarillo cultivado bajo contrato en México 2000–2005: Reflexiones sobre un programa de comercialización de granos. Cuad. Geogr. 2007, 40, 107–132. [Google Scholar]
- John, B. Genetic Diversity, Correlation, and Pathway Analysis in Composite Maize. 2025. Available online: https://www.researchgate.net/profile/Beauden-John/publication/388076062_Genetic_Diversity_Correlation_and_Pathway_Analysis_in_Composite_Maize/links/67899e1b95e02f182e975840/Genetic-Diversity-Correlation-and-Pathway-Analysis-in-Composite-Maize.pdf (accessed on 17 January 2025).
- Mex-álvarez, R.; Bolívar-Fernández, N.; Garma-Quen, P.; Tut-Heredia, J.; Romero-Guillén, K. Actividad antioxidante de cinco variedades de maíz cultivadas en campeche, México. Bol. Latinoam. Caribe Plantas Med. Aromát. 2013, 12, 558–571. [Google Scholar]
- Bani, C.; Di Lorenzo, C.; Restani, P.; Mercogliano, F.; Colombo, F. Phenolic Profile and In Vitro Antioxidant Activity of Different Corn and Rice Varieties. Plants 2023, 12, 448. [Google Scholar] [CrossRef]
- Hernández-Delgado, S.; Reyes-López, M.Á.; García-Olivares, J.G.; Mayek-Pérez, N.; Reyes-Méndez, C.A. Incidencia de hongos potencialmente toxígenos en maíz (Zea mays L.) almacenado y cultivado en el norte de Tamaulipas, México. Rev. Mex. Fitopatol. 2007, 25, 127–133. [Google Scholar]
- Baloch, N. Microbial contributions to maize crop production: A comprehensive review of challenges and future perspectives. Discov. Agric. 2025, 3, 10. [Google Scholar] [CrossRef]
- Vebliza, Y.; Sjamsuridzal, W.; Oetari, A.; Santoso, I.; Roosheroe, I.G. Re-identification of five strains of Rhizopus arrhizus from tempeh based on ITS regions of rDNA sequence data. AIP Conf. Proc. 2018, 2023, 020167. [Google Scholar]
- Akonda, M.R.; Yasmin, M.; Hossain, I. Incidence of seedborne mycoflora and their effects on germination of maize seeds. Int. J. Agron. Agric. Res. (IJAAR) 2016, 8, 87–92. [Google Scholar]
- Tsedaley, B.; Adugna, G. Detection of Fungi Infecting Maize (Zea mays L.) Seeds in Different Storages Around Jimma, Southwestern Ethiopia. J. Plant Pathol. Microbiol. 2016, 7, 1–6. [Google Scholar] [CrossRef]
- Kortekamp, A.; Schmidtke, M.; Serr, A. Infection and decay of tobacco caused by Rhizopus oryzae. Z. Pflanzenkrankh. Pflanzenschutz 2003, 110, 535–543. [Google Scholar]
- Kwon, J.H.; Kim, J.; Kim, W.I.L. First report of Rhizopus oryzae as a postharvest pathogen of apple in Korea. Mycobiology 2011, 39, 140–142. [Google Scholar] [PubMed]
- Dai, M.; Tan, X.; Chen, X.; Cai, K.; Zhong, Y.; Ye, Z.; Kong, D. Green control for inhibiting Rhizopus oryzae growth by stress factors in forage grass factory. Front. Microbiol. 2024, 15, 1437799. [Google Scholar]
- Dawlal, P.; Barros, E.; Marais, G.J. Evaluation of maize cultivars for their susceptibility towards mycotoxigenic fungi under storage conditions. J. Stored Prod. Res. 2012, 48, 114–119. [Google Scholar]
- Askun, T. Investigation of fungal species diversity of maize kernels. J. Biol. Sci. 2006, 6, 275–281. [Google Scholar]
- Hobbelen, P.H.F.; Paveley, N.D.; Van Den Bosch, F. The emergence of resistance to fungicides. PLoS ONE 2014, 9, e91910. [Google Scholar]
- Ulloa-Ogaz, A.L.; Muñoz-Castellanos, L.N. Biocontrol of phytopathogens: Antibiotic production as mechanism of control. In The Battle Against Microbial Pathogens: Basic Science, Technological Advances and Educational Programs; Formatex Research Center: Badajoz, Spain, 2015; pp. 305–309. [Google Scholar]
- Mishra, P.; Mishra, J.; Dwivedi, S.K.; Arora, N.K. Microbial enzymes in biocontrol of phytopathogens. In Microbial Enzymes: Roles and Applications in Industries; Springer: Berlin/Heidelberg, Germany, 2020; pp. 259–285. [Google Scholar]
- Neilands, J.B. Siderophores: Structure and function of microbial iron transport compounds. J. Biol. Chem. 1995, 270, 26723–26726. [Google Scholar]
- Santoyo, G.; Valencia-Cantero, E.; Orozco-Mosqueda Ma del, C.; Peña-Cabriales, J.J.; Farías-Rodríguez, R. Role of siderophores in antagonic activity of Pseudomonas fluorescens ZUM80 against plant fungi. Terra Latinoam. 2010, 28, 53–60. [Google Scholar]
- Berry, C.; Fernando, W.G.D.; Loewen, P.C.; de Kievit, T.R. Lipopeptides are essential for Pseudomonas sp. DF41 biocontrol of Sclerotinia sclerotiorum. Biol. Control 2010, 55, 211–218. [Google Scholar]
- Yu, X.; Ai, C.; Xin, L.; Zhou, G. The siderophore-producing bacterium, Bacillus subtilis CAS15, has a biocontrol effect on Fusarium wilt and promotes the growth of pepper. Eur. J. Soil Biol. 2011, 47, 138–145. [Google Scholar] [CrossRef]
- Abdelwahab, R.; Bensidhoum, L.; Tabli, N.; Bouaoud, Y.; Naili, F.; Cristina, C.; Nabti, E. A Pseudomonas protegens with high antifungal activity protects apple fruits against Botrytis cinerea gray mold. Int. J. Sci. Res. Sci. Technol. 2016, 2, 227–237. [Google Scholar]
- Bernabé-Pérez, E.A.; Gaytán, P.; Juárez-González, V.R.; Hernández-García, I.J.; Tapia-Pastrana, G.; Quintero-Hernández, V.; Martínez-Martínez, L.L. Heterologous Production of Bacteriocin EMM1 from Pseudomonas Protegens and its Antimicrobial Activity against Multidrug-resistant Clinical Isolates. Int. J. Pept. Res. Ther. 2024, 30, 73. [Google Scholar]
- Brown, D. A mathematical model of the Gac/Rsm quorum sensing network in Pseudomonas fluorescens. BioSystems 2010, 101, 200–212. [Google Scholar] [PubMed]
- Lapouge, K.; Schubert, M.; Allain, F.H.T.; Haas, D. Gac/Rsm signal transduction pathway of γ-proteobacteria: From RNA recognition to regulation of social behaviour. Mol. Microbiol. 2008, 67, 241–253. [Google Scholar]
- Sanders, E.R. Aseptic laboratory techniques: Plating methods. J. Vis. Exp. 2012, 63, e3064. [Google Scholar] [CrossRef]
- Wang, F.; Zhang, Q. In vitro inhibition of Saprolegnia sp. by an antifungal peptide from Pseudomonas protegens XL03. N. Am. J. Aquac. 2017, 79, 168–175. [Google Scholar]
- Notz, R.; Maurhofer, M.; Dubach, H.; Haas, D.; Défago, G. Fusaric acid-producing strains of Fusarium oxysporum alter 2,4-diacetylphloroglucinol biosynthetic gene expression in Pseudomonas fluorescens CHA0 in vitro and in the rhizosphere of wheat. Appl. Environ. Microbiol. 2002, 68, 2229–2235. [Google Scholar]
- Lopez-Guerrero, M.G.; Wang, P.; Phares, F.; Schachtman, D.P.; Alvarez, S.; van Dijk, K. A glass bead semi-hydroponic system for intact maize root exudate analysis and phenotyping. Plant Methods 2022, 18, 25. [Google Scholar]
- Setten, L.; Soto, G.; Mozzicafreddo, M.; Fox, A.R.; Lisi, C.; Cuccioloni, M.; Angeletti, M.; Pagano, E.; Díaz-Paleo, A.; Ayub, N.D. Engineering Pseudomonas protegens Pf-5 for Nitrogen Fixation and its Application to Improve Plant Growth under Nitrogen-Deficient Conditions. PLoS ONE 2013, 8, e63666. [Google Scholar]
- Fox, A.R.; Soto, G.; Valverde, C.; Russo, D.; Lagares, A.; Zorreguieta, Á.; Alleva, K.; Pascuan, C.; Frare, R.; Mercado-Blanco, J.; et al. Major cereal crops benefit from biological nitrogen fixation when inoculated with the nitrogen-fixing bacterium Pseudomonas protegens Pf-5 X940. Environ. Microbiol. 2016, 18, 3522–3534. [Google Scholar]
- Bukhat, S.; Imran, A.; Javaid, S.; Shahid, M.; Majeed, A.; Naqqash, T. Communication of plants with microbial world: Exploring the regulatory networks for PGPR mediated defense signaling. Microbiol. Res. 2020, 238, 126486. [Google Scholar] [CrossRef]
- Hassen, A.I.; Labuschagne, N. Root colonization and growth enhancement in wheat and tomato by rhizobacteria isolated from the rhizoplane of grasses. World J. Microbiol. Biotechnol. 2010, 26, 1837–1846. [Google Scholar]
- Yang, K.; Wang, H.; Luo, L.; Zhu, S.; Huang, H.; Wei, Z.; Zhu, Y.; Guo, L.; He, X. Effects of different soil moisture on the growth, quality, and root rot disease of organic Panax notoginseng cultivated under pine forests. J. Environ. Manag. 2023, 329, 117069. [Google Scholar]
- Balthazar, C.; St-Onge, R.; Léger, G.; Lamarre, S.G.; Joly, D.L.; Filion, M. Pyoluteorin and 2,4-diacetylphloroglucinol are major contributors to Pseudomonas protegens Pf-5 biocontrol against Botrytis cinerea in cannabis. Front. Microbiol. 2022, 13, 945498. [Google Scholar]
- Andreolli, M.; Zapparoli, G.; Angelini, E.; Lucchetta, G.; Lampis, S.; Vallini, G. Pseudomonas protegens MP12: A plant growth-promoting endophytic bacterium with broad-spectrum antifungal activity against grapevine phytopathogens. Microbiol. Res. 2019, 219, 123–131. [Google Scholar] [CrossRef] [PubMed]
- Castro Tapia, M.P.; Madariaga Burrows, R.P.; Ruiz Sepúlveda, B.; Vargas Concha, M.; Vera Palma, C.; Moya-Elizondo, E.A. Antagonistic Activity of Chilean Strains of Pseudomonas protegens Against Fungi Causing Crown and Root Rot of Wheat (Triticum aestivum L.). Front. Plant Sci. 2020, 11, 951. [Google Scholar]
- Ueda, A.; Ogasawara, S.; Horiuchi, K. Identification of the genes controlling biofilm formation in the plant commensal Pseudomonas protegens Pf-5. Arch. Microbiol. 2020, 202, 2453–2459. [Google Scholar]
- Heredia-Ponce, Z.; de Vicente, A.; Cazorla, F.M.; Gutiérrez-Barranquero, J.A. Beyond the wall: Exopolysaccharides in the biofilm lifestyle of pathogenic and beneficial plant-associated pseudomonas. Microorganisms 2021, 9, 445. [Google Scholar] [CrossRef]
- De la Vega-Camarillo, E.; Sotelo-Aguilar, J.; Rios-Galicia, B.; Mercado-Flores, Y.; Arteaga-Garibay, R.; Villa-Tanaca, L.; Hernández-Rodríguez, C. Promotion of the growth and yield of Zea mays by synthetic microbial communities from Jala maize. Front. Microbiol. 2023, 14, 1167839. [Google Scholar]
- Mercado-Vargas, T.; ChávezDíaz, I.; Zelaya-Molina, L.; Aragón-Magadán, M.; Ceballos-Alvarez, A.; Reséndiz-Venado, Z. Potencial agrobiotecnológico de Pseudomonas protegens en diferentes cultivos mexicanos. Cienc. Tecnol. Agrop. México 2022, 10, 29–35. [Google Scholar]
- Molina-Romero, D.; Bustillos-Cristales MD, R.; Rodríguez-Andrade, O.; Morales-García, Y.E.; Santiago-Saenz, Y.; Castañeda-Lucio, M.; Muñoz-Rojas, J. Mecanismos de fitoestimulación por rizobacterias, aislamientos en América y potencial biotecnológico. Biológicas 2015, 17, 24–34. [Google Scholar]
- Molina-romero, D.; Morales-García, Y.; Hernandez-Tenorio, A.; Castañeda-Lucio, M.; Netzahuatl-Muñoz, A.; Muñoz-Rojas, J. Pseudomonas putida estimula el crecimiento de maíz en función de la temperatura. Rev. Iberoam. Cienc. 2017, 4, 80–88. [Google Scholar]
- Validov, S.; Mavrodi, O.; La Fuente, L.D.; Boronin, A.; Weller, D.; Thomashow, L.; Mavrodi, D. Antagonistic activity among 2,4-diacetylphloroglucinol-producing fluorescent Pseudomonas spp. FEMS Microbiol. Lett. 2005, 242, 249–256. [Google Scholar] [PubMed]
- Jang, J.Y.; Yang, S.Y.; Kim, Y.C.; Lee, C.W.; Park, M.S.; Kim, J.C.; Kim, I.S. Identification of Orfamide A as an Insecticidal Metabolite Produced by Pseudomonas protegens F6. J. Agric. Food Chem. 2013, 61, 6786–6791. [Google Scholar] [PubMed]
- Olorunleke, F.E.; Khuong, G.; Hua, H.; Kieu, N.P.; Ma, Z.; Höfte, M. Interplay between orfamides, sessilins and phenazines in the control of Rhizoctonia diseases by Pseudomonas sp. CMR12a. Environ. Microbiol. Rep. 2015, 7, 774–781. [Google Scholar]
- Levenfors, J.J.; Nord, C.; Bjerketorp, J.; Ståhlberg, J.; Larsson, R.; Guss, B.; Öberg, B.; Broberg, A. Antibacterial pyrrolidinyl and piperidinyl substituted 2,4-diacetylphloroglucinols from Pseudomonas protegens UP46. J. Antibiot. 2020, 73, 739–747. [Google Scholar]
- Siddiqui, I.A.; Shaukat, S.S. Suppression of root-knot disease by Pseudomonas fluorescens CHA0 in tomato: Importance of bacterial secondary metabolite, 2,4-diacetylpholoroglucinol. Soil Biol. Biochem. 2003, 35, 1615–1623. [Google Scholar]

| R. Oryzae EMM Inhibition (%) | ||||
|---|---|---|---|---|
| 24 h | 48 h | 72 h | 96 h | |
| P. protegens EMM-1 | 11.5 a | 64.3 c | 72.1 d | 83.1 d |
| Double layer | Simultaneous inhibition | |||
| P. protegens EMM-1 | 1.9 a mm | 9.0 b mm | ||
| Region | Type | From | To | Most Similar Known Cluster | Similarity (%) |
|---|---|---|---|---|---|
| 1.1 | NRP-Metallophore | 1 | 79,402 | Pf-5 pyoverdine | 40 |
| 18.1 | NRPS | 127,730 | 202,218 | orfamide A | 94 |
| 21.1 | T3PKS | 111,433 | 147,971 | 2,4-diacetylpoloroglucinol | 100 |
| 31.1 | Other | 1 | 40,770 | pyrrolnitrin | 100 |
| 31.2 | NRPS | 129,658 | 156,887 | enantio-pyochelin | 60 |
| 77.1 | Arylpolyene | 1 | 38,410 | APE Vf | 40 |
| 102.1 | T1PKS | 5341 | 10,638 | pyoluteorin | 100 |
| 104.1 | NRPS | 53,410 | 105,438 | Pf-5 pyoverdine | 21 |
Disclaimer/Publisher’s Note: The statements, opinions and data contained in all publications are solely those of the individual author(s) and contributor(s) and not of MDPI and/or the editor(s). MDPI and/or the editor(s) disclaim responsibility for any injury to people or property resulting from any ideas, methods, instructions or products referred to in the content. |
© 2025 by the authors. Licensee MDPI, Basel, Switzerland. This article is an open access article distributed under the terms and conditions of the Creative Commons Attribution (CC BY) license (https://creativecommons.org/licenses/by/4.0/).
Share and Cite
Morales-Barron, B.M.; Larios-Serrato, V.; Morales-García, Y.E.; Quintero-Hernández, V.; Estrada-de los Santos, P.; Muñoz-Rojas, J. Effect of Pseudomonas protegens EMM-1 Against Rhizopus oryzae in Interactions with Mexican Autochthonous Red Maize. Life 2025, 15, 554. https://doi.org/10.3390/life15040554
Morales-Barron BM, Larios-Serrato V, Morales-García YE, Quintero-Hernández V, Estrada-de los Santos P, Muñoz-Rojas J. Effect of Pseudomonas protegens EMM-1 Against Rhizopus oryzae in Interactions with Mexican Autochthonous Red Maize. Life. 2025; 15(4):554. https://doi.org/10.3390/life15040554
Chicago/Turabian StyleMorales-Barron, Bruce Manuel, Violeta Larios-Serrato, Yolanda Elizabeth Morales-García, Verónica Quintero-Hernández, Paulina Estrada-de los Santos, and Jesús Muñoz-Rojas. 2025. "Effect of Pseudomonas protegens EMM-1 Against Rhizopus oryzae in Interactions with Mexican Autochthonous Red Maize" Life 15, no. 4: 554. https://doi.org/10.3390/life15040554
APA StyleMorales-Barron, B. M., Larios-Serrato, V., Morales-García, Y. E., Quintero-Hernández, V., Estrada-de los Santos, P., & Muñoz-Rojas, J. (2025). Effect of Pseudomonas protegens EMM-1 Against Rhizopus oryzae in Interactions with Mexican Autochthonous Red Maize. Life, 15(4), 554. https://doi.org/10.3390/life15040554

